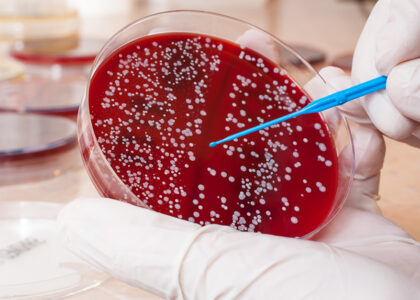

Global Staphylococcus Aureus Testing Market to Reach USD 7,668.5 Million by 2035 Amid Surge in Antibiotic-Resistant Infections and Advancements in Rapid Diagnostics | FMI
The global staphylococcus aureus testing market is poised for robust growth, expanding from approximately USD